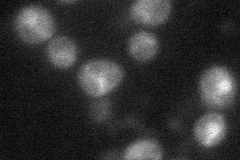

View description
Catalytic subunit of the mitochondrial inner membrane peptidase complex, required for maturation of mitochondrial proteins of the intermembrane space; complex contains Imp1p and Imp2p (both catalytic subunits), and Som1p
Localization:
Intensity:
Fold change:
Significance:
-
C’ GFP library in SD

below threshold18.72 -
N' NOP1pr-GFP in SD
cytosol,punctate32.0783 -
N' TEF2pr-mCherry in SD

ambiguous6.90325 -
N' NATIVEpr-GFP in SD

below threshold18.2572 -
N' TEF2pr-VC and Cyto-VN in SD

#N/A0 -
C’ GFP library in SD+DTT

cytosol17.610.94No -
C’ GFP library in SD+H2O2

cytosol15.280.81No -
C’ GFP library in Starvation Media

cytosol16.860.9No -
C’ GFP library on the background of Pup2-DaMP

below threshold -
C’ GFP library on the background of CCT mutant

below threshold15.86070.847021No
